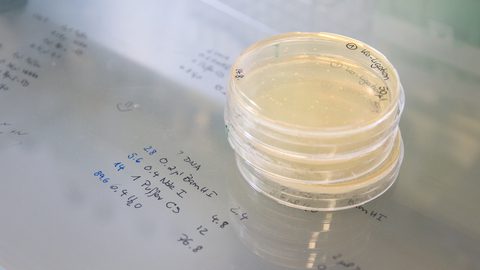
IMG 9641 hell 16 9

Flexible Work Packages for Enzyme Development

Flexible Entry Points – Start Anywhere
Customers can engage at any stage of their journey. Just tap into one or more of the modules, from early enzyme discovery and engineering to microbial expression, production strain development, bioprocess development and full-scale commercial manufacturing.
End-to-End Integration – One Partner with the end in mind
Seamlessly link enzyme development, bioprocess development, and manufacturing. Reduces technical transfer risks, project delays, and costs compared to working with multiple providers.
Advanced Toolbox – Innovative Tools for the Best Solution
Dedicated expert teams continuously implement the latest technologies (e.g. AI tools, bioinformatics) and even push the boundaries in developing proprietary technologies (e.g. MetXtra™, CRISPR-BMC, Plug & Produce) to give our customers competitive advantage.
Proven Scalability – Lab to 10,000L
Expertise and infrastructure to ensure smooth scale-up with reproducible yields and consistent quality. De-risks the transition from R&D to commercial production.
Speed to Market – Shorter Development Cycles
Experienced experts from various fields of enzyme development use state-of-the-art technologies to speed up progress and clearly defined milestones to accelerate decision-making and cut months off typical timelines.
Transparent IP & Freedom to Operate
Clear, customer-friendly IP model with no hidden licensing traps. Enables long-term security and commercial freedom for customers’ innovations.

Plug & Produce (basic): Escherichia coli: Rapid plasmid-based expression (AMR or AMR-free). Bacillus subtilis: Chromosomal integration (AMR-free) with evaluation of up to 2 constructs (e.g. signal peptide or gene design variations). Komagataella phaffii (Pichia pastoris): Evaluation of up to 2 constructs using different promoters (methanol or methanol-free induction), signal peptides, or gene designs chromosomally integrated (AMR-free).
Plug & Produce (extensive): Bacillus subtilis: Chromosomal integration (AMR-free) with evaluation of up to 6 constructs with variations in signal peptides, codon optimization, or strain genotypes. Komagataella phaffii (Pichia pastoris): Evaluation of up to 6 constructs with options for single- or multi-copy expression cassette integration. Includes promoter (methanol or methanol-free induction), signal peptide, and gene design variations. Aspergillus niger: Evaluation of up to 4 constructs with refined gene designs or signal peptides. Directed chromosomal multi-copy expression cassette integration (AMR-free). In all cases, the enzyme production will be validated via SDS-PAGE.
Plug & Produce (basic): Escherichia coli: Rapid plasmid-based expression (AMR or AMR-free). Bacillus subtilis: Chromosomal integration (AMR-free) with evaluation of up to 2 constructs (e.g. signal peptide or gene design variations). Komagataella phaffii (Pichia pastoris): Evaluation of up to 2 constructs using different promoters (methanol or methanol-free induction), signal peptides, or gene designs chromosomally integrated (AMR-free).
Plug & Produce (extensive): Bacillus subtilis: Chromosomal integration (AMR-free) with evaluation of up to 6 constructs with variations in signal peptides, codon optimization, or strain genotypes. Komagataella phaffii (Pichia pastoris): Evaluation of up to 6 constructs with options for single- or multi-copy expression cassette integration. Includes promoter (methanol or methanol-free induction), signal peptide, and gene design variations. Aspergillus niger: Evaluation of up to 4 constructs with refined gene designs or signal peptides. Directed chromosomal multi-copy expression cassette integration (AMR-free). In all cases, the enzyme production will be validated via SDS-PAGE.



Not every project starts from discovery - and it doesn’t need to. Whether your enzyme was developed in-house or elsewhere, our scale up and fermentation team can take it from proven concept to full-scale production. With extensive expertise in process transfer, optimisation, and downstream processing, we ensure reliable & high-yield manufacture.

Not every project starts from discovery - and it doesn’t need to. Whether your enzyme was developed in-house or elsewhere, our scale up and fermentation team can take it from proven concept to full-scale production. With extensive expertise in process transfer, optimisation, and downstream processing, we ensure reliable & high-yield manufacture.












Whether you’re starting with discovery, exploring diversity, or scaling up for commercialisation, our team is here to help. With flexible work packages, proven platforms, and deep scientific expertise, we’ll tailor the right solution for your project.